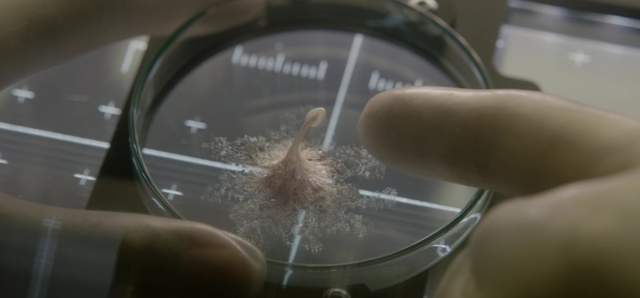
圖片5 圖片5

電影《異星智慧》預告 傑克葛倫霍x萊恩雷諾斯(逆可)(大誤)

看到這部電影也是在講「第一類接觸」。首先就想到~等等,前一陣子不是已經有另外一部敘述人類與外星人第一類接觸的電影《異星入境(Arrival)》了嗎?現在又有一部第一類接觸,加上聖誕節時還有一部只有兩個人類在茫茫宇宙中飄流的《星際過客(The Passenger)》,科幻類影迷今年底開始會很忙囉 XD 既然之前已經介紹過《異星入境》和《星際過客》,那麼今天就來看最新發布了預告的《異星智慧(Life)》吧!
原汁原味的內容在這裡話說《異星智慧》由《震撼擂台》傑克葛倫霍

圖片來自:youtube.com
與《死侍》萊恩雷諾斯兩人主演,這兩個常常都是單獨當主角的明星,這次把他們兩人湊在一起,真是難以想像他們能擦出什麼樣的火花。

圖片來自:youtube.com
說到人類與外星人的「第一類接觸」,就不能不想到幾年前那部我還滿喜歡但是票房慘不忍睹的《超級戰艦》~小狄友人也不喜歡那部電影,理由是「人類對宇宙發送信號呼叫外星人,然後外星人來了就把人家一砲打死了,到底什麼邏輯」,不過裡面有句台詞我讓我印象深刻,是蕾哈娜的角色說的「我爺爺常說~有一天人類會碰到外星人,希望那時我已經死了」。我們拍了無數人類碰到外星人、人類跟外星人抗爭、或是人類跟外星人友好相處的影片,但到底現實生活中,我們第一次碰到外星人會是什麼樣子呢?
《異星智慧》裡的外星生物長這樣

圖片來自:youtube.com
搞不好我們以後碰到的外星人真的會有觸手也說不定
圖片來自:youtube.com
或是觸角.....

圖片來自:www.youtube.com
算了,我們還是回來看《異星智慧》到底再講什麼吧。

圖片來自:youtube.com
《異星智慧》故事敘述六名太空站太空人正在執行人類史上最先進也是歷史性的任務:從火星上獲取首次完整得到的外星生物細胞。但是很快的,這種生物證明了他不但有智慧,而且可能遠比人類以為的更聰明......
這六名太空人分別是
傑克葛倫霍

圖片來自:youtube.com
萊恩雷諾斯

圖片來自:youtube.com
Olga Dihovichnaya

圖片來自:youtube.com
《不可能的任務:失控國度》Rebecca Ferguson

圖片來自:youtube.com
以及從預告看來已經領便當的Ariyon Bakare

圖片來自:youtube.com
果然,黑人就是會先死。這部電影還有真田廣之,有沒有人要跟我賭賭看他會不會是下一個掛掉的?

圖片來自:youtube.com
《異星智慧》電影預告
《異星智慧》電影由《狡兔計畫(Safe House)》Daniel Espinosa執導。
2017年6月起,看死侍燒外星人啦!

圖片來自:youtube.com部分資料來自網路 ( collider.com )











































